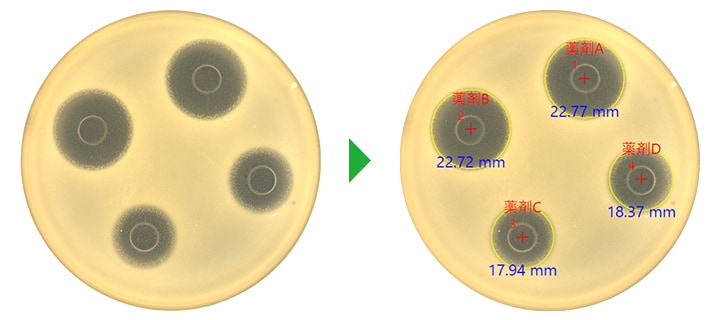

阻止円の寸法測定
- 分類:
- 難易度の高い寸法測定

薬剤感受性試験で阻止円を正確に測定するには?
ウイルスや細菌、カビや原虫などの病原微生物によって引き起こされる、風邪や食中毒などの感染症。その原因となる病原微生物を総称して「病原体」と呼びます。それらは大気や水、土壌や動物などに潜んでおり、人体に侵入することでさまざまな病気を引き起こすことが知られています。
その感染経路や感染源はさまざまですが、治療には抗菌薬(抗生物質または抗生剤)が使用されます。しかし、抗菌薬は種類によって有効な病原体が異なるため、最適なものを投与しなければ効果がないばかりか、副作用によって苦しむことさえあります。また、近年は耐性菌(薬剤耐性菌)と呼ばれる抗菌剤に抵抗力を持った病原体も増加しており、投与には細心の注意を払う必要があります。
そこで重要なのが感染症を引き起こしている病原体を特定し、有効な抗菌薬を投与することです。そのために医薬品メーカの研究部門や臨床の現場では「薬剤感受性試験」が行われています。こちらでは医薬品業界や医療現場では欠かせない薬剤感受性試験の概要、ディスク拡散法試験の手法、阻止円の測定方法についてご説明します。
薬剤感受性試験とは

薬剤感受性試験とは、感染症に対する抗菌薬の有効性を判断する試験です。まず患者から採取した病変に潜んでいる原因菌を分離して培養します。その培養した原因菌を使って数種類の抗菌薬を試験し、それぞれの有効性を判断。最終的に最適な抗菌薬を選択する基準となる非常に重要な試験と言えるでしょう。
薬剤感受性試験には「ディスク拡散法」「微量液体希釈法」など、さまざまな方法がありますが、医薬品業界や臨床の現場では広くディスク拡散法が用いられています。そこで今回はディスク拡散法に絞ってご説明します。
ディスク拡散法とは

ディスク拡散法とは、薬剤含有ディスク(薬剤を染み込ませた乾燥濾紙)を用いた薬剤感受性試験です。まず培地(培養基:微生物の培養に用いる物質)の上に薬剤含有ディスクを置き、培地中の水分を吸収させます。すると水分を伝ってディスクを中心に薬剤が拡散します。
病原体や抗菌薬によっても多少異なりますが、その状態で1日ほど培養します。薬剤が原因菌に対して有効であれば、ディスクの周囲では原因菌が発育せず、阻止円(菌が繁殖していない円)が現れます。この阻止円によって薬剤感受性を判断します。
ディスク拡散法の流れ
ディスク拡散法は、米国のCLSI(臨床検査標準化協会(旧NCCLS):Clinical and Laboratory Standards Institute)に準じて行われます。一般的には採取した病原体を使い、以下のように検査を実施します。
- 滅菌生理食塩水に菌を浮遊させ、Mcfarland 0.5濃度になるように溶かし、細菌懸濁液をつくります。
- 滅菌綿棒に細菌懸濁液を染み込ませ、ミューラーヒントン寒天培地に3回3方向から塗りつけます。
- 間隔をあけて薬剤含有ディスクを培地に配置します。
- 37℃で16~18時間ほど培養します。増殖スピードの早い病原体の場合は6時間程度で阻止円が確認できます。
阻止円とは

阻止円とは、ディスク周辺に現れる菌が繁殖していない円状のエリアを指します。ディスク拡散法では形成された阻止円の直径を測定し、ディスクに添付されている判定表に従って「感受性(S:Susceptible)」「中間(I:Intermediate)」「耐性(R:Resistant)」を判定します。ただし、抗菌薬の種類によって特性が異なるので、必ずしも阻止円が大きいから感受性が高いというわけではありません。必ず使用するディスクの判定表を確認ください。
薬剤感受性試験によって感受性と判定された場合は、原因菌はその薬剤に対して治療上問題となる耐性メカニズムを有していないと判断できます。そのため患者に投与し、感染部位に十分な濃度で分布すれば原因菌の増殖を抑える、または殺菌作用によって改善が望める可能性があります。
阻止円の測定方法

阻止円の直径はノギスや定規などを使って測定します。肉眼で判別できる病原体が発育している場所の境界を基準に形成された阻止円をmm単位で測定。菌の種類によって測定方法は異なりますが、一般的に完全に菌の発育が阻止できている範囲を阻止円としてみなします。

阻止円測定時の問題点
前述のように阻止円はノギスや定規などを使って手作業で測定しますが、そこにはさまざまな問題点が潜んでいます。
- 手作業で測定するので誤差が生じやすい
- 測定者によって誤差が発生しやすい
- 楕円形などの阻止円では測定箇所によって誤差が発生する
- 極小の阻止円を正確に測定することが難しい
- 接触測定のため測定機器に病原菌が付着する可能性がある
- アナログな測定方法のため、データインテグリティへの対応が難しい
上記のように測定誤差はもちろんですが、細菌を測定対象としているため安全性への配慮も非常に重要です。万全を期しているとはいえ、接触式の測定方法では細菌に触れてしまう可能性も排除できず、細菌が付着した測定器を使用することで試験担当者への感染を生じさせるリスクがあります。他の試験サンプルへのコンタミネーションが生じれば、本来の正しい結果が得られず判断を誤らせる恐れもあります。
非接触で正確な寸法を測定するには
さまざまな課題のある阻止円測定ですが、その解決手段としてご提案したいのが高精度自動コロニーカウンターBCシリーズです。ノギスや定規から置き替えることで測定者による誤差も排除でき、常に一定の測定データを取得することができます。また、薬剤ごとに判定表の基準値が登録できるため、測定結果をもとにSIR判定結果を表示させることも可能です。
また薬剤感受性試験では複数のディスクを使い、それぞれの阻止円を測定する必要があるので手間がかかっていました。しかし、高精度自動コロニーカウンターBCシリーズであれば16箇所までの測定を同時に行うことが可能です。そのため、すべての阻止円の直径を一度の測定で把握することができます。測定対象のディスクを指定したら、あとはボタンを押すだけと操作も簡単で、時間もかかりません。
また、測定結果は本体に自動保存され、ワンクリックで測定前と測定後の画像を含んだレポートも作成できるので、測定結果をパソコンに入力することも不要。画像の撮影から測定のための各種設定、測定結果のデータ化などすべての作業を専用アプリケーション上で一貫して行うことができ、セキュリティ機能を用いれば管理者・測定者などのユーザアカウント設定や操作ログの記録(監査証跡)も可能で、データインテグリティへの対応も万全です。これまで手間と時間がかかっていた薬剤感受性試験ですが、高精度自動コロニーカウンターBCシリーズがあれば阻止円測定を簡略化でき、正確でスピーディな試験が実現するだけでなく、信頼性の高いデータ管理も可能となります。
医療・医薬品関係者の方で「薬剤感受性試験の手間を減らしたい」というご要望、またそれ以外にも観測・測定に関するご要望、ご相談などがございましたら下記よりお申し込みください。









